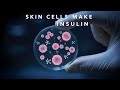
Scientists Just Created INSULIN From Skin Cells

- Популярные видео
- Авто
- Видео-блоги
- ДТП, аварии
- Для маленьких
- Еда, напитки
- Животные
- Закон и право
- Знаменитости
- Игры
- Искусство
- Комедии
- Красота, мода
- Кулинария, рецепты
- Люди
- Мото
- Музыка
- Мультфильмы
- Наука, технологии
- Новости
- Образование
- Политика
- Праздники
- Приколы
- Природа
- Происшествия
- Путешествия
- Развлечения
- Ржач
- Семья
- Сериалы
- Спорт
- Стиль жизни
- ТВ передачи
- Танцы
- Технологии
- Товары
- Ужасы
- Фильмы
- Шоу-бизнес
- Юмор
T1D Trials: My 43-Year Journey Through Success & Failure
Diamyd and the Diagnode-3 trial sadly have failed. ⚠️ The DIAGNODE-3 trial results are in — and they're not what the T1D community was hoping for.
Diamyd Medical's GAD-alum vaccine trial has concluded, and today I'm breaking down exactly what happened, what the data actually says, and what this means for the future of Type 1 Diabetes research and treatment.
This isn't clickbait — this is a reality check on where we stand, backed by the official data.
🔬 In this video:
- What DIAGNODE-3 was designed to do
- What the results actually showed
- Why this outcome matters for the broader T1D vaccine pipeline
- What comes next for the community
I've lived with Type 1 Diabetes for 43 years. I follow every serious step forward — and every setback — so you don't have to dig through the science alone.
💬 Drop your thoughts in the comments. How do you feel about this result?
🔔 Subscribe for real T1D science — no hype, no scams, just facts.
Get vidIQ to grow your channel faster! 🚀
https://vidiq.com/Type1Diabeticwar
Видео T1D Trials: My 43-Year Journey Through Success & Failure канала Type-1 Diabetic Warriors
Diamyd Medical's GAD-alum vaccine trial has concluded, and today I'm breaking down exactly what happened, what the data actually says, and what this means for the future of Type 1 Diabetes research and treatment.
This isn't clickbait — this is a reality check on where we stand, backed by the official data.
🔬 In this video:
- What DIAGNODE-3 was designed to do
- What the results actually showed
- Why this outcome matters for the broader T1D vaccine pipeline
- What comes next for the community
I've lived with Type 1 Diabetes for 43 years. I follow every serious step forward — and every setback — so you don't have to dig through the science alone.
💬 Drop your thoughts in the comments. How do you feel about this result?
🔔 Subscribe for real T1D science — no hype, no scams, just facts.
Get vidIQ to grow your channel faster! 🚀
https://vidiq.com/Type1Diabeticwar
Видео T1D Trials: My 43-Year Journey Through Success & Failure канала Type-1 Diabetic Warriors
diabetes type 1 diabetes clinical trials diamyd medical Diamyd clinical trials Diagnode-3 clinical results medicine Diabetes type-1 T1D insulin vaccine diabetes vaccine type 1 diabetes news T1D news diabetes research type 1 diabetes clinical trial clinical trial DIAGNODE-3 Diamyd Medical type 1 diabetes cure T1D clinical trial diabetes treatment type 1 diabetes 2026 T1D Warriors
Комментарии отсутствуют
Информация о видео
31 марта 2026 г. 19:00:07
00:00:51
Другие видео канала